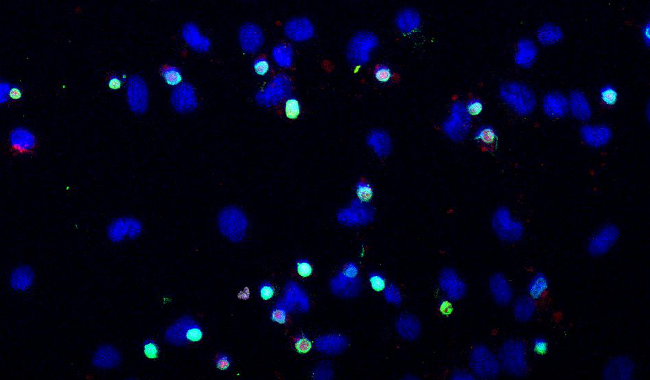

貨號(hào):30005

|
產(chǎn)品名稱(chēng)
|
規(guī)格(張)
|
|
|
30005
|
TUNEL圖像分析
|
單張,或250張
|
研究導(dǎo)致DNA損傷及其后果的機(jī)制,是更好地了解人類(lèi)疾病的一個(gè)寶貴的信息來(lái)源。TDT介導(dǎo)dUTP缺口末端標(biāo)記(TUNEL)染色觀察這一過(guò)程,在凋亡、壞死和其他DNA損傷相關(guān)的過(guò)程中有及其重要的作用。它的有效性有利于篩選大量的細(xì)胞培養(yǎng),需要對(duì)海量的圖像處理。

ICP備案號(hào):
滬ICP備15057650號(hào)-1
滬公網(wǎng)安備31011202005471
雷萌生物科技(上海)有限公司 保留所有版權(quán).